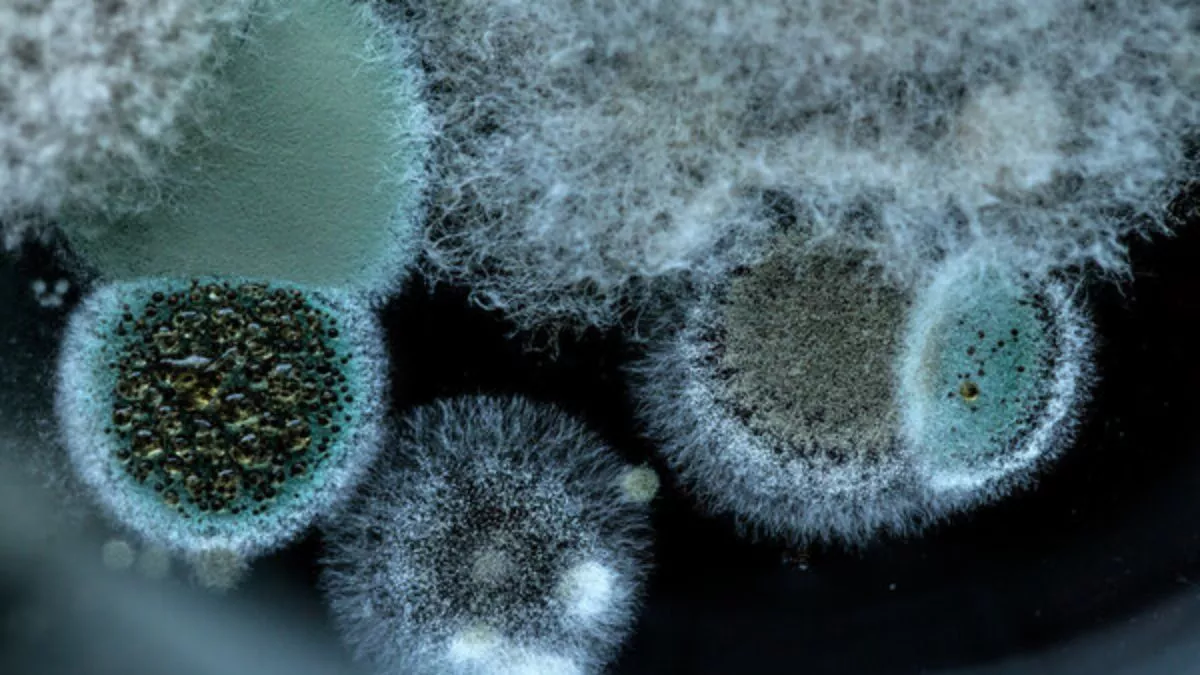

Курил плесень
Курил плесень 107 фотографий
Песня папа фейс
Мусе манарову
Брендовые костюм мужские интернет магазин
Что вреднее сигареты айкос или вейпы
Материал из красных водорослей
Международный демократический институт
День сошествия духа
Tp link high gain 150 mbps
Партийные лозунги
Телефон краснодарского роспотребнадзора
Технопоинт днс комсомольск на амуре каталог товаров
Алкашка магазин
Читать книгу я подарю тебе измену
Орленок хранитель исторической памяти 2025
Петля пружинная двойная
21 21 время на часах ангельская нумерология
Лимит выводы превышен кс маркет
2 комн квартира в новгороде
Пиксельные сражения
Как называется химическая связь показанная на рисунке